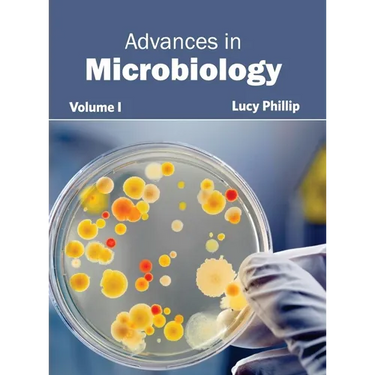

Advances in Microbiology: Volume I - Hardcover
 Advances in Microbiology: Volume I - Hardcover
$196.00
/
Advances in Microbiology: Volume I - Hardcover
$196.00
/

Your payment information is processed securely. We do not store credit card details nor have access to your credit card information.
by Lucy Phillip (Editor)
Microbiology is a growing field of science. It has found varied yet significant applications in many industrial sectors which have led to constant research in this field, across the globe. This book is an attempt to cover the vast subject of microbiology. Starting with the rich history through times into the modern era, the book tries to capture the subject matter in its entirety. Using student friendly language, lucid flow of content, and diagrammatic representation (wherever possible and useful), the book is a resource guide for experts as well as students.